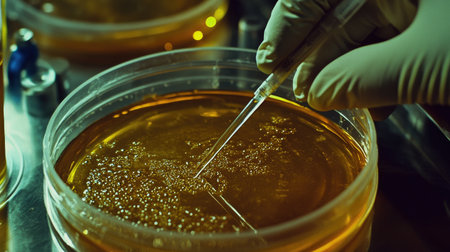
Bacteria being streaked on agar plates with sterile tools in a microbiology lab.の素材

素材 - Bacteria being streaked on agar plates with sterile tools in a microbiology lab.
作品情報
Bacteria being streaked on agar plates with sterile tools in a microbiology lab.
- ID:257419034
- 作品種別:
- 作者名:Phattarasaya Glubpis
キーワード
- agar
- analysis
- analyzing
- antibiotic
- background
- bacterial
- biochemistry
- biology
- biotechnology
- blood
- chemical
- colony
- color image
- culture
- disease
- dish
- equipment
- experiment
- growth
- health
- healthcare and medicine
- horizontal
- infection
- laboratory
- medical research
- medical test
- medicals
- medicine
- medium
- micro
- microbiology
- one person
- organism
- people
- petri
- petri dish
- plate
- research
- sample
- science
- scientific experiment
- scientist
- stem - topic
- streak
- technician
- technology
- test
- virus
類似作品
Microbiology.
macro of bacter...
detail of bacte...
Backgrounds of ...
Backgrounds of ...
bacteria colony...
Shower head wit...
Colony of blue ...
Colonies of dif...
Bacterial cultu...
bacterial colon...
bacteria colony...
Bacteria growin...
Backgrounds of ...
Backgrounds of ...
Backgrounds of ...
holding plate w...
Antibiotic sens...
Old vintage pho...
Study Colony ch...
Colony of bacte...
Backgrounds of ...
Bacterial cultu...
yellow colony i...
bacteria colony...
Mold Beautiful,...
Colonies bacter...
microbiology la...
Bacterial T-str...
microbial cultu...
bacteria colony...
Antibiotic Drug...
Bacterial colon...
Backgrounds of ...
Man in gloves i...
microbial cultu...
Green mold grow...
petri dish with...
sticks for hygi...
yellow colony i...
Backgrounds of ...
Colony characte...
white foam text...
abstract air bu...
Glass pipette a...
close-up of sci...
Loop for exposu...
Plant Petri on ...
Colonies of bac...